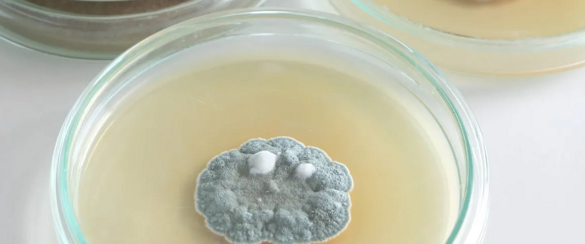
5bc49178-89de-4e8f-8ec2-ed11ff9b3be3 5bc49178-89de-4e8f-8ec2-ed11ff9b3be3

La scoperta della penicillina nel 1928 da parte dello scozzese Alexander Fleming è la più importante scoperta fortuita o accidentale della storia. Ora , una semplice ferita non avrebbe più comportato, per molti, la morte per infezione. Ora malattie devastanti come la Lebbra ed la Peste potevano essere efficacemente curate,
---------------------------------------
La prima sperimentazione di un vaccino antivaioloso lo dobbiamo al medico inglese Edward Jenner: era l'anno 1776.
IL PRIMO VACCINO DELLA STORIA UMANA LO SI DEVE A LUI.
A Unità d'Italia avvenuta, la vaccinazione antivaiolosa fu resa obbligatoria per tutti i nuovi nati a partire dal 1888. L'obbligo è stato abolito in Italia nel 1981, dopo che nel maggio 1979 l'Organizzazione Mondiale della Sanità, OMS, ha decretato eradicato il vaiolo dalla Terra.
Il Vaiolo era una malattia contagiosa di origine virale, dichiarata eradicata nel 1980, grazie alla vaccinazione. È stata una delle malattie più devastanti conosciute dall'umanità e ha causato milioni di morti prima di essere eradicata. Si ritiene che fosse esistita da almeno 3000 anni.
Non esiste una cura per il vaiolo, ma la vaccinazione può essere utilizzata in modo molto efficace per prevenire lo sviluppo dell'infezione, se somministrata durante un periodo fino a quattro giorni dopo che una persona è stata esposta al virus.
Il vaiolo colpì molte famiglie reali: morirono a causa di questa malattia un imperatore austriaco e un imperatore cinese, un re di Spagna e una regina di Svezia e, ancora, Luigi XV di Francia e lo zar Pietro II di Russia. Anche il re Sole, Luigi XIV, si ammalò di vaiolo, ma non gravemente.

Oggi la medicina è in grado di identificare e curare moltissime malattie, la vita media si è innalzata in relativamente poco tempo, e ci sono specialisti di ogni genere a cui possiamo affidarci. Ma non è sempre sta - to così, anzi. La medicina è una scienza che negli ultimi anni ha fatto progressi enormi, e il dott. Michael Mosley è pronto a raccontarceli. In questo episodio si parla di infezioni. Milioni di persone sono morte a causa di complicanze di un'infezione nel corso della storia, e il dott. Mosley ricostruisce per noi il modo in cui siamo riusciti a comprendere l'esistenza dei batteri e dei virus e a combatterli.
La scoperta della penicillina avvenne per puro caso: durante i primi anni del Novecento la convinzione che ci fossero agenti micotici che potessero aiutare l'uomo a difendersi da altri germi patogeni era diffusa, ma non provata. La ricerca in questo senso languiva senza poter produrre effetti utili.
Il punto di svolta si ebbe quando nel 1928 Alexander Fleming, microbiologo inglese, nel suo laboratorio di St. Martin, a Londra, verificando lo stato di una coltura di batteri, vi trovò una copertura di muffa. Questo evento non aveva nulla di straordinario, poiché erano normali situazioni del genere; la cosa eccezionale fu invece il fatto che questa muffa aveva annientato tutti i Batteri circostanti.
Fleming identificò la muffa come appartenente al genere Penicillium notatum che in italiano si traduce con "pennello notevole", dalla forma degli sporofori.
La scoperta fu casuale; infatti, se si fosse trattato di un altro tipo di germi, o di un altro tipo di muffa, o più semplicemente di uno scienziato più distratto, probabilmente tutto sarebbe passato inosservato.
La scoperta non suscitò all'epoca grande entusiasmo, anche perché la penicillina non curava molte altre malattie, tra cui la più banale influenza, non immunizzava e soprattutto non eliminava definitivamente i batteri, ma li "stordiva", in attesa che il sistema immunitario si organizzasse per combatterli e distruggerli. Inoltre, essendo eliminata piuttosto velocemente, erano necessarie diverse somministrazioni giornaliere per ottenere l'effetto desiderato.
Il risultato degli primi studi confermò che l’estratto di muffa manteneva la stessa capacità antibatterica attesa così ben preso, i risultati si sostituirono allo scetticismo iniziale e l’estratto entrò in uso sperimentale proprio con il nome ufficiale di penicillina.
Nel 1941 però successe qualcosa che dimostrò, invece, l'efficacia reale di questo ritrovato. In un ospedale di Oxford, durante la guerra, era ricoverato un poliziotto che stava per morire di Setticemia a causa di una piccola ferita infetta al lato della bocca.
Rivelatesi inutili le somministrazioni di sulfamidici, al poliziotto venne iniettata una dose di penicillina di 200 mg. Accanto al suo letto non c'era Fleming, ma i suoi due collaboratori Chain e Florey; un netto miglioramento cominciò a vedersi. Purtroppo, le scorte di penicillina si esaurirono e il poliziotto morì, ma l'efficacia del farmaco contro le infezioni fu definitivamente dimostrato. In Gran Bretagna e negli USA cominciò una massiccia produzione del preparato.
-----------------------------------------------------------------------------------------
LA LOTTA AL VAIOLO E LA PRATICA DEL VACCINO
La medicina occidentale era impotente di fronte alla malattia, quindi non esistevano veri e propri metodi di cura. Si prescrivevano diete, si tenevano le navi in quarantena, si vietavano spostamenti e contatti fra le persone in periodo di contagio. Fra le teorie più stravaganti si pensava che il colore rosso funzionasse da trattamento terapeutico per i colpiti da vaiolo, un rimedio che sembra risalire a pratiche giapponesi del 10° secolo. Ancora durante un'epidemia del 1902 nello Smallpox hospital di Boston venne adoperata questa terapia: i pazienti, vestiti con pigiami rossi, erano confinati in stanze dipinte di rosso con tende rosse e venivano loro somministrate bevande rosse.
Le dicerie popolari, confermate dall'esperienza, mostravano che il morbo non si prendeva mai due volte. Avendo notato che molti degli schiavi provenienti dall'Oriente che avevano sul viso i segni della malattia ne erano immuni, si poteva tentare di provocare artificialmente la malattia in forma benigna, sperando così di proteggere un soggetto sano da ulteriori contaminazioni. Da questa constatazione era nata la pratica dell'inoculazione, messa in atto da secoli in Persia e in India, dove era di privilegio esclusivo dei bramini. In Cina l'inoculazione è documentata nel 590 a.C.: il medico prelevava delle croste secche da un malato non grave, le polverizzava e soffiava la polvere ottenuta nelle narici di persone sane. Circa il 2% delle persone inoculate, tuttavia, si ammalavano gravemente.
Talvolta la pratica diffondeva il morbo perché non venivano prese misure di isolamento. La tecnica, detta anche di vaiolizzazione, ebbe pure altre varianti. Perlopiù si procedeva al prelievo da un malato di pus vaioloso, che veniva trasmesso a un soggetto sano per via cutanea (con un filo, una piccola incisione, una scarnificazione o un'iniezione). L'infezione veniva trasmessa anche attraverso le mucose nasali mediante fazzolettini impregnati di pus, o facendo inalare le croste in polvere come prese di tabacco o attraverso una pipa. In Georgia e in Circassia, dove molte giovani donne venivano vendute per rifornire gli harem della Turchia, quest'ultima pratica era adoperata comunemente per evitare che l'eventuale malattia le potesse sfigurare. In Turchia l'operazione dell'inoculazione aveva luogo in un contesto di cerimonie tradizionali, dove una donna più anziana provvedeva a inoculare le più giovani. L'introduzione della pratica trovò forti resistenze in Occidente, anche se esistono testimonianze del suo uso sporadico in Spagna, dove sembra essere stata introdotta dagli arabi, e in Danimarca, dove venne introdotta alla fine del Seicento dall'anatomista Th. Bartolinus. Nel 1774 il medico francese Th. Tronchin inoculò il re Luigi XVI infilandogli sotto la pelle un filo che aveva fatto passare attraverso una pustola di un convalescente. La regina si sottopose al procedimento solo dopo averlo fatto sperimentare su sei condannati a morte.
Tradizionalmente il merito di aver diffuso il metodo in Inghilterra è attribuito a M. Wortley Montagu, moglie dell'ambasciatore inglese a Costantinopoli. Donna intelligente e curiosa, la Montagu aveva imparato un po' il turco ed era venuta a conoscenza della pratica dell'inoculazione. Particolarmente sensibile al problema, essendo stata in parte sfigurata dalla malattia pochi anni prima, descrisse accuratamente la pratica in diverse lettere indirizzate in Inghilterra. In Turchia fece inoculare suo figlio di 3 anni e a Londra nel 1721, allo scoppio di un'epidemia, sottopose allo stesso trattamento la figlia di 5 anni. I tentativi della Montagu di diffondere la pratica arrivarono alla famiglia reale e re Giorgio I fece sperimentare l'inoculazione su sei condannati a morte: si ammalarono solo lievemente e ottennero in cambio la libertà. Nel 1722 il medico di corte C. Aymand inoculò la principessa Amelia di 11 anni e la principessa Carolina di 9, oltre ai propri figli e a numerosi membri della nobiltà inglese. La pratica si diffuse successivamente in tutta Europa: nel 1749 in Olanda, nel 1750 in Germania, nel 1755 in Francia. Per molti anni però continuarono le discussioni e le controversie sulla sua utilità e soprattutto sull'innocuità del procedimento. L'inoculazione rappresentò comunque la scoperta pratica di un processo immunitario.
Un nuovo capitolo della lotta al vaiolo è rappresentato dalla vaccinazione. La storia della medicina ne attribuisce la paternità a un medico inglese, E. Jenner, ma anche altri ne hanno rivendicato la scoperta. Si sapeva che le vacche trasmettevano un morbo simile al vaiolo alle mani delle contadine che le mungevano. Ma si sapeva anche che quelle ragazze divenivano immuni dal vaiolo, tanto che in Inghilterra era famosa la bellezza delle contadine addette alla mungitura, probabilmente perché non avevano il viso sfigurato da piaghe. Tuttavia studi sistematici sul fenomeno non erano mai stati compiuti. Jenner iniziò i propri studi sulla relazione tra la malattia che colpiva le vacche (cowpox) e il vaiolo che colpiva gli uomini nel 1778. Notò soprattutto che le persone infettate dal vaiolo vaccino resistevano anche all'inoculazione, il che faceva ipotizzare che fossero protette dalla malattia. Le ricerche durarono quasi vent'anni e solo nel 1796 Jenner si decise a sperimentare la sua ipotesi. Prelevò del pus dalla mano di una giovane mungitrice e lo trasmise su un bambino sano di 8 anni, che non era stato mai inoculato. All'incirca un mese e mezzo dopo inoculò il piccolo ripetutamente con pus proveniente da una pustola infetta, ma egli rimase immune. L'inoculazione fu ritentata dopo diversi mesi, ma di nuovo il bambino rimase immune. Una pubblicazione sull'esperimento fu presentata da Jenner alla Royal society, ma non venne accettata.
Due anni dopo l'esperimento, nel 1798, Jenner pubblicò un libro dal titolo An inquiry into the causes and effects of the variolae vaccinae, in cui descriveva il suo procedimento, che venne denominato vaccinazione dall'origine del materiale infettivo. Il procedimento di Jenner ebbe successo e si diffuse in Europa abbastanza velocemente, anche se con il tempo vennero rilevati alcuni inconvenienti, come la perdita progressiva dell'efficacia del vaccino umano e soprattutto il rischio di altre malattie infettive che derivava dalla pratica della vaccinazione da braccia a braccia. Napoleone fece vaccinare tutti i suoi soldati nel 1805, e dal 1807 tutti i bambini bavaresi dovevano obbligatoriamente essere vaccinati. La Norvegia rese obbligatoria la vaccinazione nel 1810, la Svezia nel 1815, l'Inghilterra nel 1867, la Danimarca nel 1871, la Germania nel 1874. La lotta contro questa malattia nel Novecento, una volta realizzato che il morbo non si conserva nell'uomo, è stata sempre più efficace. Nel 1967, tuttavia, la malattia era ancora endemica in 33 paesi con quasi quindici milioni di ammalati ogni anno. Una campagna dell'Organizzazione mondiale della sanità, durata più di dieci anni, sembra oggi aver eradicato definitivamente la malattia: l'ultimo caso segnalato è del 1977 in Somalia. La campagna è costata circa cento milioni di dollari e vi hanno contribuito in modo sostanziale gli Stati Uniti e l'Unione Sovietica.